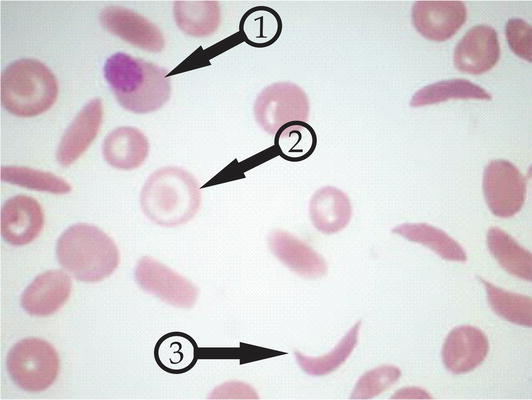

KOREKCIJA ENGLESKOG JEZIKA I PARAFRAZIRANJE
Precizna korekcija engleskog jezika Vašeg rukopisa uz očuvanje naučnog značenja pre slanja u naučni časopis. Parafraziranje kako biste izbegli odbijanje rada zbog plagijarizma ili autoplagijarizma (teksta koji ste napisali slično ili isto kao u nekom Vašem prethodnom radu).
ŠEMATSKI PRIKAZI
Izrađujemo sve vrste šematskih prikaza, kao i prilagođavanje i unapređenje postojećih šema, u skladu sa zahtevima vrhunskih naučnih časopisa. Šeme su jasno strukturisane, vizuelno ujednačene i tehnički precizne, sa ciljem da se na profesionalan način prikažu eksperimentalni postupci, mehanizmi i koncepti.
FOTOGRAFIJE I GRAFIKONI
Pripremamo i unapređujemo fotografije i grafikone za naučne radove, u skladu sa tehničkim i vizuelnim zahtevima naučnih časopisa. Usluga obuhvata korekciju kvaliteta, kao i izradu grafikona koji omogućavaju precizan i pregledan prikaz eksperimentalnih rezultata.

PROFESIONALNO FOTOGRAFISANJE
Nudimo profesionalno fotografisanje uzoraka i eksperimentalnih postavki za potrebe naučnih radova i projekata, uz kontrolisano osvetljenje i visoku rezoluciju, u skladu sa zahtevima naučnih časopisa. Usluga uključuje i fotografisanje uzoraka na optičkom mikroskopu.
PRILAGOĐAVANJE STILU ČASOPISA
Prilagođavamo rukopise, figure i prateće materijale specifičnim smernicama ciljnog časopisa, uključujući strukturu teksta, formatiranje, stil citiranja i izgled figura. Na taj način se obezbeđuje da rad bude tehnički usklađen sa zahtevima časopisa i spreman za proces recenzije.
SLANJE NAUČNIH RADOVA
Proces slanja naučnih radova često je dug, zahtevan i opterećujući, uz brojne zahteve koje je potrebno ispuniti. Preuzimamo kompletnu pripremu i podnošenje rada kroz elektronske sisteme časopisa, kako bi se autori mogli u potpunosti posvetiti svom istraživanju.
POBOLJŠAJTE VAŠE RADOVE
Korekcija engleskog jezika, preformulisavanje teksta
UNAPREDITE SLIKE I GRAFIKONE
Unapređenje fotografija, grafikona, šema i profesionalna fotografija
POŠALJITE RAD BEZ MUKE
Prilagođavanje stilu časopisa, slanje naučnih radova u elektronskim sistemima časopisa
Thyone Studio &
Song Composition
Music quis lorem ut libero malesuada feugiat nulla quis lorem ut libero malesuada feugiat mauris blandit aliquet elit eget tincidunt nibh pulvinar praesent sapien massa convallis pellen tesque nec egestas non nisi curabitur non nulla sit amet nisl tempus convallis quis acim.
Music quis lorem ut libero malesuada feugiat nulla quis lorem ut libero malesuada feugiat mauris blandit aliquet elit eget tincidunt nibh pulvinar praesent sapien massa convallis pellen tesque nec egestas non nisi curabitur non nulla sit amet nisl tempus convallis quis acim.
Standardi našeg rada




Učinimo publikovanje
jednostavnijim
Proces objavljivanja naučnih radova često je složen, dugotrajan i zahteva pažnju na veliki broj detalja. Naš cilj je da taj proces učinimo jednostavnijim i efikasnijim, preuzimajući tehničke i uredničke korake umesto autora. Poverenje i zadovoljstvo naših korisnika potvrđuju kvalitet našeg rada i dugoročnu saradnju sa istraživačima sa fakulteta i instituta.

Kontaktirajte nas
TELEFON
+381 69 571 9800
office@advancedpublishing.rs